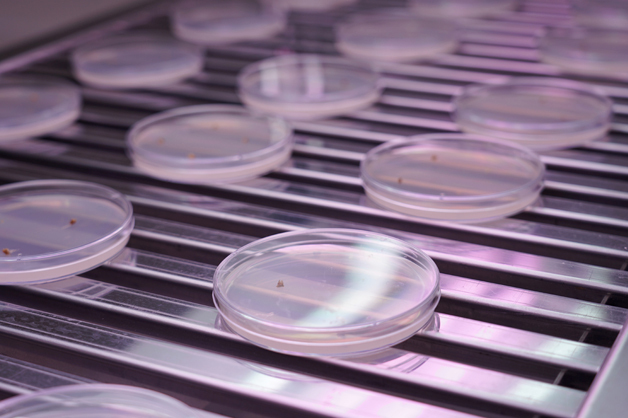

Новости
В ТГУ имени Г.Р. Державина открылась Лаборатория биотехнологии лесных культур


В Державинском университете появилась Лаборатория биотехнологии лесных культур. В лаборатории будут получать высококачественные посадочные материалы методом клонального микроразмножения для выращивания в лесах Тамбовской области.
– Это продолжение совместной работы Державинского университета и Управления лесами Тамбовской области и лесхозами, – говорит ректор ТГУ Владимир Стромов. – Новая лаборатория создана для решения задач федерального проекта «Сохранение лесов» нацпроекта «Экология». Мы регулярно открываем специализированные центры и лаборатории. Наша задача – дать студентам знания, которые они могли бы реализовать на практике. Лаборатория биотехнологии лесных культур создаст качественно новые условия для осуществления подготовки биологов и биотехнологов.
По словам директора Института естествознания ТГУ Елены Скрипниковой, новые, биотехнологические, методы размножения дают возможность получать качественные посадочные материалы. Среди них сосна, ель обыкновенная, береза, дуб, осина и др.
– Это очень трудоемкие, но эффективные методы, – отметила Елена Скрипникова. – Мы можем брать ткани элитных растений, размножать их, получать большое количество посадочного материала, адаптировать его и высаживать. По некоторым хвойным породам нет качественного размножения. И мы планируем решить эту проблему.
Еще одно направление сотрудничества ТГУ имени Г.Р. Державина и лесхозов – изучение болезней лесных культур, почвенного микробиома, агрохимических свойств почв лесопитомников. Точная диагностика возбудителей болезней лесных культур позволит разрабатывать методы эффективной защиты растений. Создание микробиологических агрохимикатов на основе наночастиц, повышающих приживаемость сеянцев и клонов в питомниках, поможет увеличить количество посадочного материала и его качество.